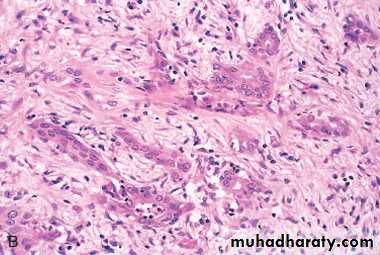

DISORDERS OF GALLBLADDER AND EXTRAHEPATIC BILIARY TRACT
GALLBLADDER DISEASESCholelithiasis (Gallstones)Gallstones trouble up to 20% of adult populations and are mainly of two types
• Cholesterol stones composed of crystalline cholesterol monohydrate (80%)
• 2. Pigment stones composed predominantly of bilirubin calcium salts (20%)
Pathogenesis and Risk Factors
Bile is a major pathway for elimination of excess cholesterol from the body.Cholesterol is rendered water soluble through mixing with bile salts and lecithins that are secreted into bile.
When cholesterol concentrations exceed the solubilizing capacity of bile (supersaturation), cholesterol deposited as solid cholesterol crystals.
• Cholesterol gallstone formation involves four concurrently occurring steps:
1. Supersaturation of the bile with cholesterol
2. Establishment of a nidus by microprecipitates of calcium salts
3. Hypomobility of the gallbladder (stasis), which promotes nidus formation
4. Mucus hypersecretion to trap the crystals and thus enhancing their aggregation
The presence of unconjugated bilirubin in the biliary tree increases the likelihood of pigment stone formation.
This occurs in hemolytic anemias and biliary tract infections. The precipitates are insoluble calcium bilirubinate salts.
The majority of individuals with gallstones (80%) have no identifying risk factors
• Contributory risk factors include1. Age and genderonly 5% of the population younger than age 40 but 25% of those older than 80 years develop stones.
The prevalence in women is about twice as high as in men.
2. Ethnic and geographic: more prevalent in Western industrialized societies and uncommon in developing ones.
3. Heredity: family history imparts increased risk, as do a variety of inborn errors of metabolism such as those associated with impaired bile salt synthesis and secretion.
4. Environment: estrogenic influences, including oral contraceptives and pregnancy, increase hepatic cholesterol uptake and synthesis, leading to excess biliary secretion of cholesterol.
5. Obesity, rapid weight loss, and treatment with the hypocholesterolemic agent clofibrate are strongly associated with increased biliary cholesterol secretion.
6. Gallbladder hypomotility predisposes to gallstones. It is associated with pregnancy, rapid weight loss, and spinal cord injury. In most cases, however, the hypomotility is present without obvious cause.
Pathologic features
Pure cholesterol stones always formed within the gall bladder as pale to tan yellow, and are ovoid and firm.They may be single but most are often multiple. In the latter instance, they assume a faceted surface from apposition to one another.
Most cholesterol stones are radiolucent, but 20%of them may have sufficient calcium carbonate to render them radiopaque.
Cholesterol gallstones
Mechanical manipulation during laparoscopic cholecystectomy has caused fragmentation of several yellow cholesterol gallstones, the interiors are black because of entrapped bile pigments. Note the faceted outlines. The gallbladder mucosa is reddened and irregular as a result of coexistent acute and chronic cholecystitis.Pigment stones may arise anywhere in the biliary tree (gall bladder, intra- or extra-hepatic bile ducts) and are either black or brown.
In general, black pigment stones are found in sterile bile, while brown stones are found in infected bile.
Black stones are usually small, present in large numbers, and crumble easily.
Brown stones tend to be single or few in number.
Because of the incorporation of calcium carbonates and phosphates, 50% to 75% of black stones are radiopaque.
Pigmented gallstones
Several faceted black gallstones are present in the gallbladder from a person with a mechanical mitral valve prosthesis, leading to chronic intravascular hemolysis.Gallstones are asymptomatic in 75% of the cases.
Pain is the principal symptom and it tends to be severe, either constant or "colicky" from an obstructed gallbladder or when small gallstones move down-stream and lodge in the biliary tree.Inflammation of the gallbladder, in association with stones, also generates pain.
Complications of gall stones include
1. Empyema
2. Perforation
3. Fistulae
4. Cholongitis
5. Obstructive cholestasis
6. Pancreatitis
It is the very small stones that are dangerous; the larger the calculi, the less likely they are to enter the cystic or common ducts to produce obstruction.
Occasionally a large stone may erode directly into an adjacent loop of small bowel, generating intestinal obstruction ("gallstone ileus").
Cholecystitis
This may be acute, chronic, or acute superimposed on chronic, and almost always occurs in association with gallstones.Gross features
Acute cholecystitisThe gallbladder is usually enlarged, tense, and bright red or blotchy, violaceous to green-black discoloration. The latter is due to subserosal hemorrhages.
The serosal covering is frequently covered by fibrin or suppurative exudate.
In 90% of cases stones are present, often obstructing the cystic duct.
The gallbladder lumen is filled with cloudy or turbid bile (contain fibrin, blood, and frank pus).
When the exudate is pure pus, the condition is referred to as empyema of the gallbladder.
Acute cholecystitis
The mucosa has a characteristic "angry red" color. Note the marked edema of the wall and the serosal hyperemia. (normally the wall is paper-thin
Acute cholecystitis showing extensive ulceration, hemorrhage, and edema & inflammation
Acute cholecystitisMicroscopical features
• The inflammatory reactions consist of the usual patterns of acute inflammation or• It may be suppurative with frank abscess formation, or eventuates in gangrenous necrosis.
Acute Calculous Cholecystit is
refers to acute inflammation of a gallbladder that contains stones and is precipitated by obstruction of the gallbladder neck or cystic duct.
It is the most common major complication of gallstones and the most common reason for emergency cholecystectomy.
Initially it is the result of chemical irritation and inflammation of the gallbladder wall in the setting of obstruction to bile outflow.
Acute Non-Calculous Cholecystitis
Up to 10% of gallbladders removed for acute cholecystitis contain no gallstones.Most of these cases occur in seriously ill patients e.g. after severe trauma such as a major surgery, motor vehicle accidents, severe burns as well as sepsis.
In such cases many events are thought to contribute to this condition such dehydration, gallbladder stasis and , vascular compromise, and, ultimately, bacterial contamination.
Chronic Cholecystitis
may be the sequel to repeated bouts of acute cholecystitis, but in most instances it develops de novo.
Like acute cholecystitis it is almost always associated with gallstones but these do not seem to have a direct role in the initiation of inflammation.
Rather, supersaturation of bile predisposes to both chronic inflammation and, in most instances, stone formation.
Microorganisms, usually E. coli and enterococci, can be cultured from the bile in only about one-third of cases.
Pathological features
The changes are extremely variable and sometimes minimal.The mere presence of stones within the gallbladder, even in the absence of acute inflammation, is often taken as sufficient justification for the diagnosis.
The gallbladder may be contracted, of normal size, or enlarged.
The submucosa and subserosa are often thickened from fibrosis.
In the absence of superimposed acute cholecystitis, mural lymphocytes are the only feature of inflammation.
There is thickening of the wall. The gallbladder is of normal size but it may be contracted, or enlarged. The mere presence of stones within the gallbladder, even in the absence of inflammation, is often taken as sufficient justification for the diagnosis.
Chronic cholecystitis with cholelithiasis
DISORDERS OF EXTRAHEPATIC BILE DUCTS
Choledocholithiasis and Cholangitis are frequently seen together.Choledocholithiasis
is the presence of stones within the biliary tree.
Almost all these stones are derived from the gallbladder.
Symptoms are absent in 10% of the cases, but when occur they are due to biliary obstruction or its sequele such as pancreatitis, cholangitis, hepatic abscess, secondary biliary cirrhosis, or acute calculous cholecystitis.
Cholangitis
refers to acute mostly bacterial inflammation of the wall of bile ducts.
Most cases are due to obstruction bile flow, mostly by choledocholithiasis.
However, surgical reconstruction of the biliary tree is also a recognized cause.
Secondary Biliary Cirrhosis
Prolonged obstruction of the extrahepatic biliary tree results in secondary biliary cirrhosis. Causes include1. Extrahepatic cholelithiasis (the most common cause)
2. Malignancies of the biliary tree and head of the pancreas
3. Strictures resulting from previous surgical procedures
4. Biliary atresia
• The initial morphologic features of cholestasis are entirely reversible with correction of the obstruction.
• However, secondary inflammation resulting from biliary obstruction initiates periportal fibrogenesis, which eventually leads to scarring and nodule formation, generating secondary biliary cirrhosis.
• Subtotal obstruction may promote ascending cholangitis, which further contributes to the damage.
• Enteric organisms such as coliforms and enterococci are common offenders.
• Ascending cholangitis refers to the tendency of bacteria, once within the biliary tree, to infect intrahepatic biliary ducts.
• The usual pathogens are E. coli, Klebsiella, Clostridium, Bacteroides, etc.
• Charcot's triad (pain, jaundice and fever) is the most common mode of presentation.
• The most severe form of cholangitis is suppurative cholangitis, in which purulent bile fills and distends bile ducts, with an attendant risk of liver abscess formation.
Biliary Atresia
is a major cause of neonatal cholestasis (30%).
Biliary atresia is defined as a complete obstruction of bile flow caused by destruction or absence of all or part of the extrahepatic bile ducts
It is the most frequent cause of death from liver disease in early childhood.
• The CLEAR features of biliary atresia include
1. Inflammatory fibrosing stricture of extrahepatic biliary tree .2. Inflammatory destruction of the major intrahepatic bile ducts
3. Features of biliary obstruction on liver biopsy4. Periportal fibrosis and cirrhosis within 3 to 6 months of birth.
liver biopsy provides evidence of bile duct obstruction in 90% of cases of biliary atresia.Without surgical intervention, death usually occurs within 2 years of birth.
TUMORS
Carcinoma of the Gallbladder is the most frequent malignant tumor of the biliary tract.It occurs most frequently in the age group 60-70 years.
The mean 5-year survival is 5% because it is rarely discovered at a resectable stage.
Gallstones are present in about 75% of the cases.
Presumably, gallbladders containing stones or infectious agents develop cancer as a result of recurrent trauma and chronic inflammation.
Gross features
The cancer is either exophytic (fungating) or infiltrative growth.
The infiltrative pattern, which is the more common, usually appears as a poorly-defined area of thickening and induration of part or whole of gall bladder wall.
The exophytic pattern grows into the lumen as cauliflower mass, but at the same time it invades the underlying wall
Adenocarcinoma of the gallbladder
The opened gallbladder contains a large, exophytic tumor that virtually fills the lumen.Malignant glandular structures are present within the gallbladder wall, which is fibrotic.
Microscopic features
Well- to poorly-differentiated infiltrative adenocarcinomas that is sometimes papillary.By the time gallbladder cancers are discovered, most have invaded the liver directly and many have extended to the cystic duct and adjacent bile ducts and lymph nodes at the portahepatis.
Preoperative diagnosis of gall bladder carcinoma is seen in only a 20% of the cases.
Preoperative diagnosis rests largely on detection of gallstones along with abnormalities in the gallbladder wall documented by imaging studies.Cholangiocarcinomas
are adenocarcinomas arising from cholangiocytes (epithelial cells lining) in bile ducts within and outside of the liver.
Extrahepatic cholangiocarcinomas (2/3 of the cases)
They occur mostly in individuals 50 to 70 years of age.
The prognosis of cholangiocarcinomas is poor because they are generally asymptomatic until late, and most patients have unresectable tumors.
Risk factors include
1. Primary sclerosing cholangitis
2. Fibrocystic diseases of the biliary tree
3. Exposure to Thorotrast (which is no longer used in radiography of the biliary tree).
Pathological features
Due to early development of obstructive jaundice, these tumors are detected as small firm, gray nodules within the bile duct wall. Alternatively, they are diffusely infiltrative lesions that create thickening of the wall.These adenocarcinomas are generally well-differentiated with an abundant fibrous stroma
Cholangiocarcinomas may spread to extrahepatic sites such as regional lymph nodes, lungs, & bones.
Mean survival time is around 12 months.
Cholangiocarcinoma
A, Massive neoplasm in the right lobe and multiple metastases throughout the liver. B, Tumor cells forming glandular structures surrounded by dense sclerotic stroma.• THE EXOCRINE PANCREAS
PANCREATITISAcute Pancreatitis is relatively common in developed countries. Causes implicated include
1. Gallstones and excessive alcohol intake; these are the main offenders.
2. Non-gallstone obstruction of the pancreatic ducts e.g. by periampullary tumors
3. Medications as with thiazide & frusemide diuretics
4. Trauma, both blunt and iatrogenic during surgery or endoscopy
5. Others such as metabolic disorders, ischemia and infections as with mumps
In up to 20% of patients there is no identifiable cause (idiopathic pancreatitis).
Gross features
In milder forms there is edema & congestion of the organ with foci of fat necrosis.Fat necrosis results from enzymatic destruction of fat cells; the released fatty acids combine with calcium to form insoluble salts that precipitate locally and appear as yellow-white chalky deposits within & outside the pancreas e.g. in the omentum and mesentery.
The peritoneal cavity contains a brown-tinged fluid with fat globules.
In the most severe forms there is extensive parenchymal necrosis accompanied by diffuse hemorrhage.
A, The microscopic field shows a region of fat necrosis (right), and focal pancreatic parenchymal necrosis (center). B, The pancreas has been sectioned longitudinally to reveal dark areas of hemorrhage in the pancreatic substance and a focal area of pale fat necrosis in the peripancreatic fat (arrow).
Acute pancreatitis
Yellow-tan foci of fat necrosis are visible throughout the hyperemic pancreas, which has been sectioned in half. There is some edema, but no hemorrhage in this case of mild acute pancreatitis.
Acute pancreatitis
The fat necrosis consists of fat cells that have lost their nuclei and whose cytoplasm has a granular pink appearance. Some hemorrhage is seen at the left in this case.
Acute pancreatitis
At high magnification, acute inflammation with necrosis and hemorrhage is seen with residual pancreatic acini in a case of acute hemorrhagic pancreatitis.
Acute hemorrhagic pancreatitis
Pathogenesis
changes favor autodigestion of the pancreatic substance by activated pancreatic enzymes.Trypsin seems to have a central role because it can activate other enzymes (e.g. phospholipases and elastases) that can participate in the process of autodigestion.
Pancreatic duct obstruction causes an increase in intraductal pressure, thus allowing accumulation of an enzyme-rich interstitial fluid that causes tissue injury.
Edema further compromises local blood flow, causing vascular insufficiency and ischemic injury to acinar cells.
The role of alcohol as a cause of pancreatitis is still unknown, proposed mechanisms include contraction of the sphincter of Oddi and direct toxic effects on acinar cells.
The manifestations of severe acute pancreatitis are attributable to systemic release of digestive enzymes and explosive activation of the inflammatory response.
Patients show increased vascular permeability, leukocytosis, DIC, ARDS (due to alveolar capillary injury), and diffuse fat necrosis.
Shock can occur rapidly due to electrolyte disturbances and loss of blood volume.
These catastrophic events can be complicated by endotoxemia resulting from infection of the necrotic debris by gram-negative organisms as there is break down of barriers between gastrointestinal, pancreas and blood stream.
Laboratory findings
include markedly elevated serum amylase during the first 24 hours, followed (within 3-4 days) by rising serum lipase levels.Hypocalcemia can result from precipitation of calcium in the extensive areas of fat necrosis.
The enlarged inflamed pancreas can be visualized by CT or MRI.
Although most individuals with acute pancreatitis eventually recover, some die from shock; ARDS and acute renal failure. In those who survive complications include pancreatic abscesses or pancreatic pseudocysts.Pancreatic Pseudocyst
is the most common cystic lesion of the pancreas and a common complication of acute pancreatitis.Liquefied necrotic pancreatic tissues become surrounded by fibrous tissue wall to form a cystic space, lacking an epithelial lining ("pseudo").
Drainage of pancreatic secretions into this space over months to years (from damaged pancreatic ducts) can cause massive enlargement of the cyst (up to 30 cm in diameter).
They can become secondarily infected, and larger pseudocysts can compress or even perforate into adjacent structures.
It is commonly attached to the surface of the gland and may involve peripancreatic tissues.
This is hardly recognizable as pancreas because a large pancreatic pseudocyst has formed. Seen here at autopsy is the opened pseudocyst extending from hilum of liver to the right of the photograph. It has an irregular red to brown to black inner surface.
Pancreatic pseudocyst
A, Cross-section revealing a poorly defined cyst with a necrotic wall. B, Histologically the cyst lacks a true epithelial lining and instead is lined by fibrin, granulation tissue, and chronic inflammation.
Pancreatic pseudocyst
Chronic Pancreatitis
longstanding inflammation and fibrosis with destruction of the exocrine pancreas; in the late stages, the islets are also lost. CausesChronic alcoholism (the most common cause).
Long-standing pancreatic duct obstruction (e.g., by pseudocysts, calculi, neoplasms)Tropical pancreatitis: seen in Africa and Asia, and attributed to malnutrition
Hereditary pancreatitis due to mutations of genes, some encoding trypsin inhibitor.
Cystic fibrosis
• In some cases there is no obvious cause (idiopathic); as with acute pancreatitis, a growing number of these cases are associated with inherited mutations in genes concerned with normal pancreatic exocrine function.
Gross features:
the gland is hard, sometimes with extremely dilated ducts and visible calcifications
Microscopic features
Parenchymal fibrosis, reduced number and size of acini, and variable dilation of the ducts.
A chronic inflammatory infiltrate around remaining lobules and ducts.
Islets of Langerhans are relatively spared but eventually they disappear.
This low power photomicrograph demonstrates scattered chronic inflammatory cells in a collagenous stroma with a few remaining islets of Langerhans in a case of chronic pancreatitis. Chronic alcoholism is a common cause for this condition.
Chronic pancreatitis
A, Extensive fibrosis and atrophy has left only residual islets (left) and ducts (right), with a sprinkling of chronic inflammatory cells and acinar tissue. B, A higher power view demonstrating dilated ducts with inspissated eosinophilic concretions in a patient with alcoholic chronic pancreatitis.
Chronic pancreatitis
Pathogenesis
This is still not established with certainity. However, several hypotheses are proposed:1. Ductal obstruction by concretions: alcohol increases the protein concentration of pancreatic secretions; these can form ductal plugs.
2. Toxic: alcohol can exert a direct toxic effect on acinar cells leading to their destruction
3. Oxidative stress induced by alcohol generates free radicals in acinar cells, with resulting acinar cell necrosis, inflammation, and fibrosis.
4. Necrosis-fibrosis due to recurrent episodes of acute pancreatitis
Chronic pancreatitis can present with repeated bouts of jaundice, persistent or recurrent abdominal and back pain.
It may be entirely silent until pancreatic insufficiency and diabetes develop.
Chronic pancreatitis may present as attacks of abdominal pain with some elevation of serum amylase.
Gallstone-induced obstruction may cause jaundice &/or elevation in serum alkaline phosphatase.
A helpful finding is visualization of calcifications within the pancreas by CT or ultrasonography.
Weight loss and hypoalbuminemia with edema from malabsorption can also occur.
PANCREATIC NEOPLASMS
Cystic NeoplasmsSome of these are entirely benign (e.g., serous cystadenoma); others, such as mucinous cystic neoplasms, can be benign but frequently have malignant potential.
Pancreatic Carcinoma has a very poor prognosis in that the 5-year survival rate is less than 5%.
Pathogenesis:
There is a progressive accumulation of genetic changes in pancreatic epithelium as it proceeds from non-neoplastic, to noninvasive lesions in small ducts and ductules, to invasive carcinoma.Antecedent lesions are called "pancreatic intraepithelial neoplasias" (PanINs). They are often found adjacent to infiltrating carcinomas and share with the latter a number of the same genetic mutations.
The more common molecular alterations in pancreatic carcinogenesis affect K-RAS (oncogene), and the tumor suppressor genes p16, SMAD4, and p53.
Carcinoma is primarily a disease of the elderly (60 and 80 years).
Smoking has the strongest environmental influence.
Chronic pancreatitis and diabetes mellitus are also associated with an increased risk.
Familial clustering of pancreatic cancer has been reported, and familial pancreatitis (related to mutations in a trypsinogen gene) is associated with up to 80-fold increased risk.
Gross features
The head is most commonly involved (60%), whereas the tail is the least common site (5%)
The cancer is usually hard, gray-white, poorly defined mass.
Most carcinomas of the head obstruct the distal common bile duct leading to distention of the biliary tree, and obstructive jaundice.
In marked contrast, carcinomas of the body and tail do not interrupt the biliary tract and hence remain silent for some time. They may be quite large and widely disseminated by the time of the diagnosis.
The regional lymph nodes & the liver are often involved by metastases as are the lungs & bones.
A, A cross-section through the head of the pancreas and adjacent common bile duct showing both an ill-defined mass in the pancreatic substance (arrowheads) and the green discoloration of the duct resulting from total obstruction of bile flow. B, Poorly formed glands are present in a densely fibrotic (desmoplastic) stroma within the pancreatic substance.
Carcinoma of the pancreas